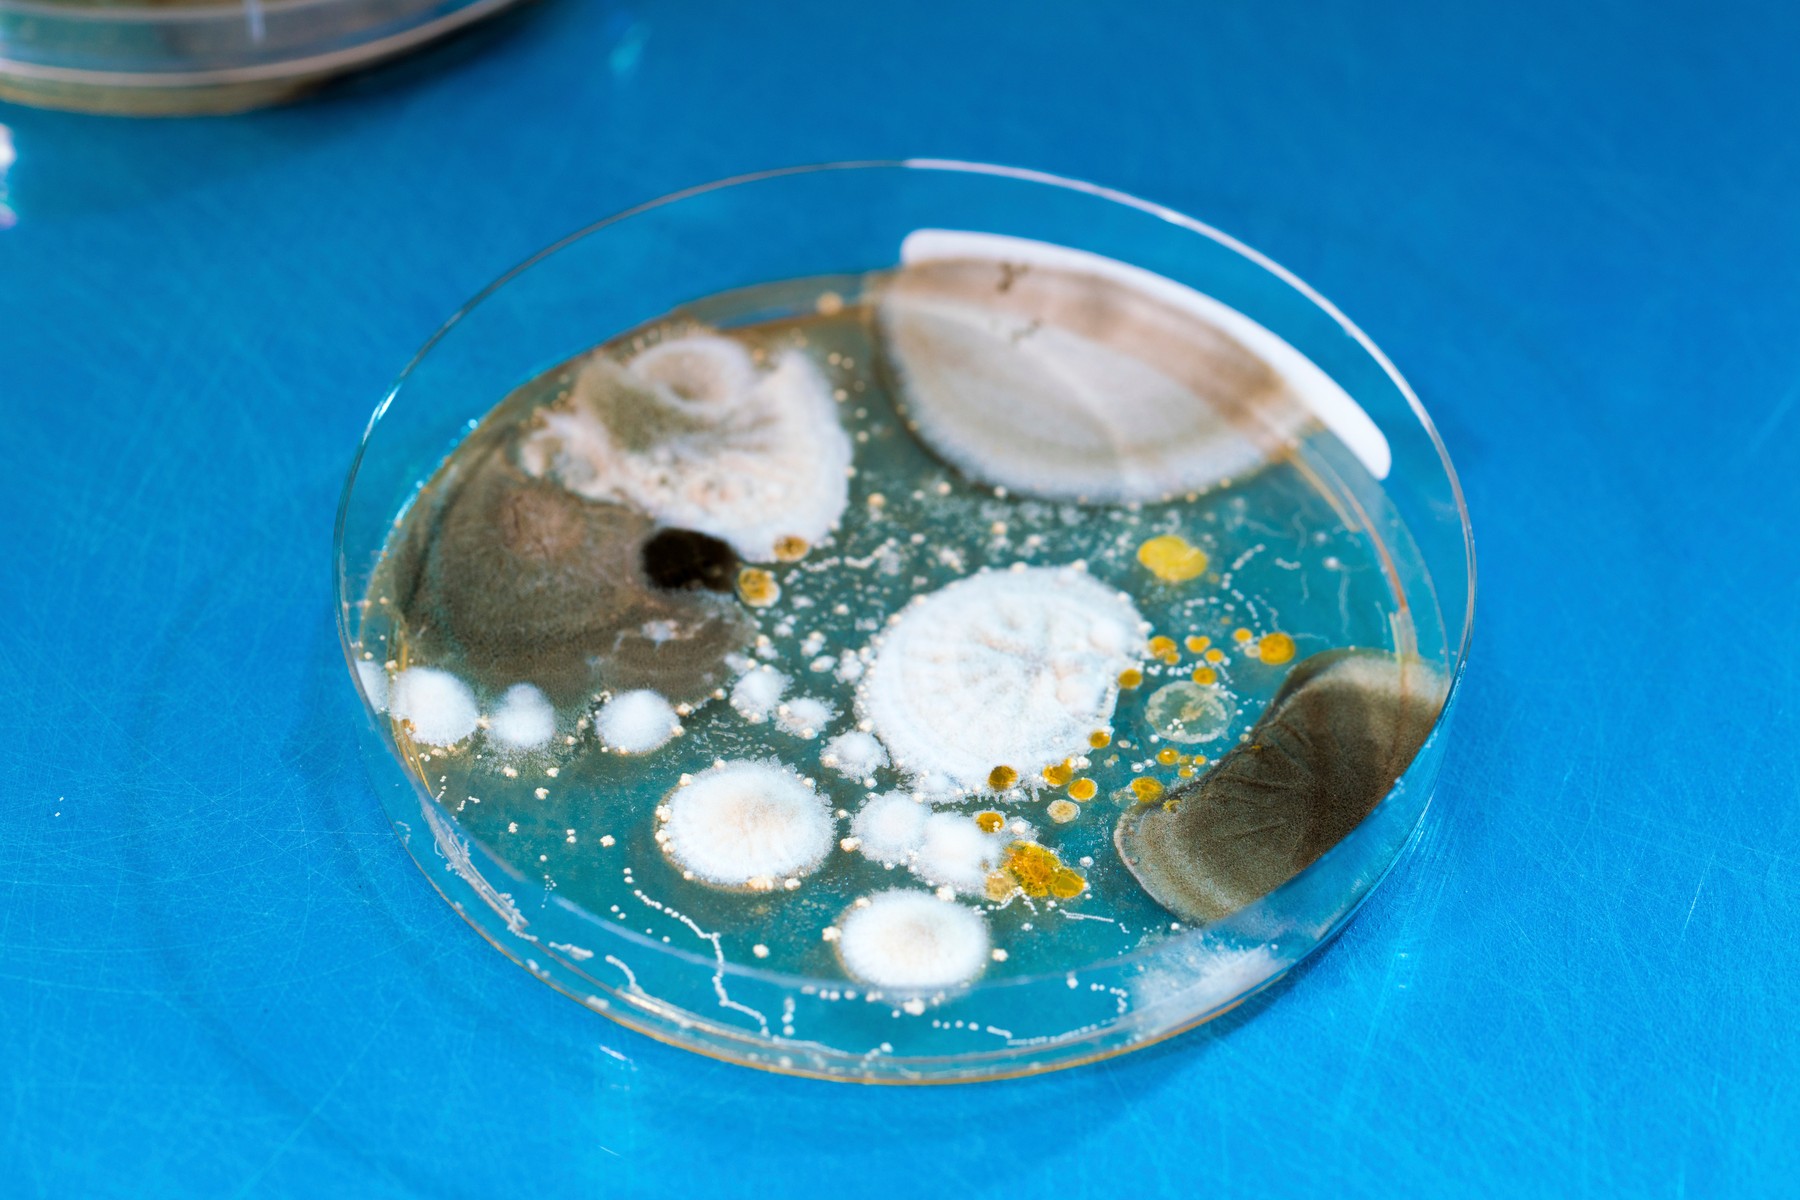
plijesan, bakterije

Mislite da morate razbiti zid da provjerite ima li plijesni u vašem domu? Ne trebate. Zapravo postoji vrlo jednostavan način da provjerite ima li plijesni u vašem domu - a potrebno je samo 30 sekundi.
Kako provjeriti imate li plijesni?
Otvorite poklopac vodokotlića i provjerite donju stranu. Ako tamo vidite plijesan, to može značiti da imate plijesan negdje u kući koja osigurava spore potrebne za početak rasta nove plijesni u vašem vodokotliću.
Iako bi pomislili da je to mjesto na kojem bi se sigurno skupljala plijesan, to nije točno. Sam poklopac vodokotlića je težak, ali nije hermetički zatvoren, što znači da ne dopušta veliku izmjenu zraka.
Takav mali protok zraka znači da je moguće da spore plijesni pronađu svoj put unutra, ali šanse za to su prilično male. Međutim, kolonizirana plijesan unutar kuće oslobađa veliku količinu spora u zrak - mnogo više nego što bi prirodno plijesni bilo prisutno.
Više spora znači da se šanse za rast plijesni u spremniku povećavaju. Zato povremeno provjeravanje vodokotlića može vas upozoriti na veći problem plijesni u vašem domu. Ako je ima unutra, bilo je dovoljno spora u zraku da oportunistički pronađu put do vašeg vodokotlića.
Vrsta plijesni koja se nalazi u vodokotlićima u potpunosti ovisi o tome koje su vrste plijesni prisutne u vašem domu. Aspergillus ili Penicillium neke su od najčešćih, ali s toliko dosad identificiranih vrsta, bilo koja od njih može biti prisutna.
Takav veliki broj vrsta također znači da plijesan unutar vodokotlića može biti različitih boja, od ružičaste ili smećkaste do crne i zelene, kao i niz tekstura, poput baršunaste ili puderaste, piše 24sata.
Zašto je WC tako dobro mjesto za provjeru plijesni?
Da biste shvatili zašto ovaj mali trik funkcionira, morate razumjeti samu plijesan - koja se zapravo sastoji od dvije stvari. Prvo, to je sitna čestica koja se naziva spora plijesni. Kada se spora plijesni unese u vodu, izvor života, ona postaje drugi dio: živi organizam. Ovaj proces je sličan načinu na koji sjemenke postaju biljke.
Plijesan (sada živi organizam) se razmnožava stvaranjem više spora koje se prenose zrakom i traže vodu. Zapamtite, baš kao i sjeme, ove spore nisu živi organizmi sve dok ne pronađu taj izvor vode.
Ovo je važan za razumjeti jer dok govorimo o tome gdje pronaći plijesan u vašem domu, mi tražimo živi organizam. S dosad identificiranih više od sto tisuća vrsta plijesni, spore plijesni prisutne su posvuda. One su unutar vašeg doma, lebde oko vašeg automobila i zalijepljene su za dlaku vašeg psa.
To je neizbježna životna činjenica i dio ekosustava. Spore same po sebi neće uzrokovati problem u vašem domu, osim ako vaš dom ima izvor vode za oportunistički rast.
Zato su čišćenje i pročišćavanje zraka važni kako bi se smanjio broj nakupljenih spora u kući i smanjila mogućnost porasta vlage.
Ako u vodokotliću imate plijesan, to bi mogao biti znak većeg problema s plijesni s izvorom ili izvorima negdje u kući koji proizvode spore. U najmanju ruku, pronalaženje plijesni u vlastitom WC-u je jasan znak da se negdje u domu nalazi plijesan koja otpušta puno spora.
Što učiniti ako u spremniku pronađete plijesan?
Ako pronađete plijesan u vodokotliću, najprije se riješite tog problema pomoću odgovarajućih proizvoda i metoda čišćenja.
Onda je idealno potražiti pomoć inspektora za plijesan koji će detaljno pregledati vaš dom, koristeći različite mjerne tehnike i prikupljajući niz podataka od vrsta plijesni do razine mikotoksina i bakterija.
Sveobuhvatna inspekcija nažalost može biti prilično skupa, ali isplati se dobiti točnu sliku stanja vašeg doma piše MindBodyGreen. Zamislite to kao da idete liječniku i trebate krvnu sliku i druge pretrage za dijagnosticiranje bolesti. Vjerojatno nećete štedjeti na troškovima ako vam pomogne da se bolje osjećate.
Sljedeći put kad budete u kupaonici, svakako zavirite u vodokotlić! Rano uočavanje plijesni može vam dugoročno uštedjeti mnogo novaca, a i smanjiti potencijalne zdravstvene probleme vas i ukućana te osigurati da je kvaliteta zraka u vašem domu sigurna i zdrava.
N1 pratite putem aplikacija za Android | iPhone/iPad i društvenih mreža Twitter | Facebook | Instagram.
Kakvo je tvoje mišljenje o ovome?
Pridruži se raspravi ili pročitaj komentare